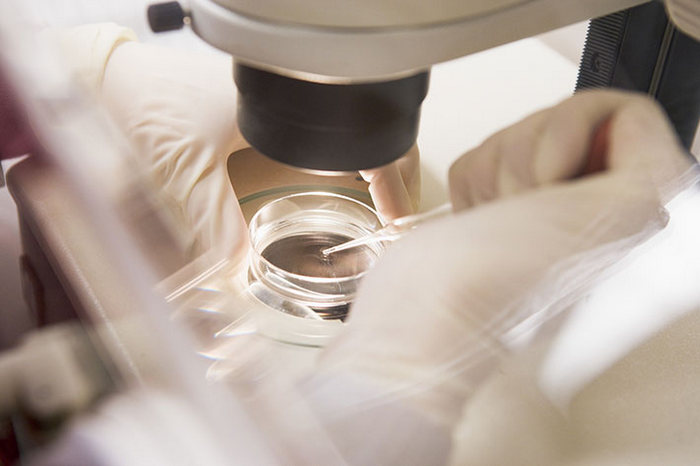
ICSI

From the very beginning days of IVF, it was a method to treat infertility in female participants. With the development of technology over time, IVF treatments now, also includes methods to address and treat male factor infertility.
To understand how male factor infertility occurs and how to treat it, one has to know how does fertilization of egg happens. During the process of fertilization, the fastest sperm cell reaches the egg first. This sperm cell then proceeds penetrating the egg cell and dies while penetrating the egg membrane. During the process of trying to penetrate the egg, the sperm cell helped loosen the oocyte membrane. Soon after the membrane is broken down enough, one of the approaching sperm cell (contrary to popular belief, not the fastest) can penetrate the egg and fertilize it. The hole, through which the sperm cell entered the egg membrane, closes right after fertilization.

ICSI is advised for
ICSI is a procedure which can help address male infertility during the IVF procedure, but which kind of male infertility in particular can be addressed with ICSI? It is important to note that for the procedure to be carried out there is a need of only one sperm cell for the egg cell to be fertilized. Hence most fertility experts will advise ICSI when:
- When the sperm cell count in the ejaculation is very low.
- When the sperm cells in the seamen are either abnormal in some ways or the motility of the sperm cells is very low.
- When the sperm cells had to be retrieved surgically due to various medical reasons related to male infertility.
- When the semen of the patient contains antibodies in very high levels, which is the major factor affecting natural fertilization.
- ICSI is also recommended to patients who’s sperms shows signs of DNA damage.
- ICSI is also recommended when the patients previous fertilization attempts naturally have led to poor or no results.
While ICSI seems to be an ideal method, its important to note that it is a method that sidesteps the natural process where millions of sperms compete and a best of the one is selected. Due to this it is not recommended to use ICSI, unless one of the above mentioned conditions is occurring in the patient/ patients.
The process of ICSI sometimes, actually rarely comes to a situation when there are no eggs available or the eggs get damaged during the process of injection, which makes the egg unfit for further procedure. This case happens statistically less than 10 percent of the time. The problem in both these cases is the quality of the egg and not that of the sperm and hence the risk posed is higher from female factor than male. Statistically ICSI has a very low rate of failure, with less than 1-3 percent of failure rates.

ICSI at GMS IVF
Based on the fertilization process described above, it is understood that for fertilization to occur, male sperm should have a certain amount of active sperm cells (motile) or else none of them will make the journey through the vaginal cavity all the way to the egg cell. But what can be done if there aren’t enough active sperm cells or if the sperms cells are not motile enough? ICSI is a type of technology that can help men through the IVF process. A more detailed list of when is ICSI needed is in next section.
ICSI or «Intra Cytoplasmic Sperm Injection», also known as intracellular sperm injection, is one of the auxiliary stages of in vitro fertilization. The procedure consists of an embryologist choosing only the best, most active sperm cell (as embryologists like to refer to it «the most beautiful») from the patient’s collected sperm. The sperm cell is then immobilized with a special tiny needle under an electron microscope. This immobilized sperm cell is then helped into the egg by injecting it directly into the egg cell. With this method, ONLY ONE sperm cell is necessary to complete the fertilization process instead hundreds or millions, which is the natural process.

appointment Will be glad to answer any of your questions
- РУ
- EN
- CN






